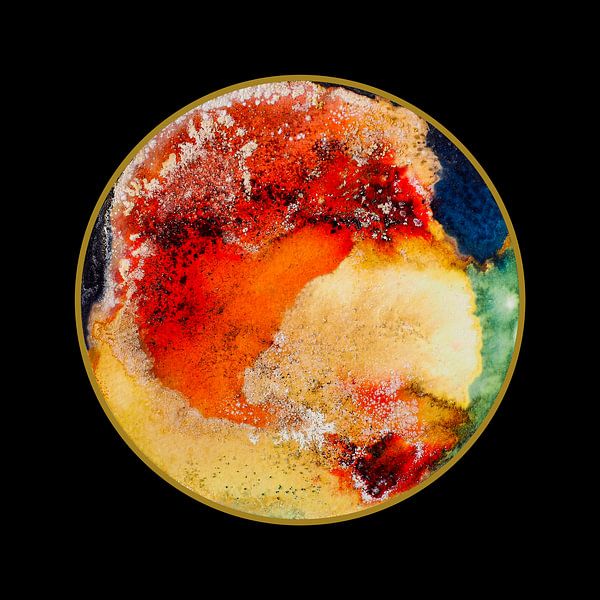
Into the mystic - 29 by Natasja Vugts

We work with several carriers, mainly UPS and DHL (Depending on the country where it is delivered, this may vary). Couriers can also be used for large or fragile packages.
Canvas are securely packed in plastic bubble wrap and cardboard. Wallpaper and posters are sent in sturdy tubes.
A courier collects the package from us and takes the package to a depot where it usually stays overnight. The day after it is collected and delivered to your home or office. We work with courier services that specialise in handling fragile parcels.
Not at home? Then the delivery driver will leave a note and an appointment can be made to schedule a new delivery.
Unfortunately, there remains a chance that something can happen during a shipment. In the unlikely event that your parcel has been damaged during transit, please take a picture of the entire item, the damage, the entire package and a picture of the shipping label. Send these photos to us by email and we will solve the problem without delay.